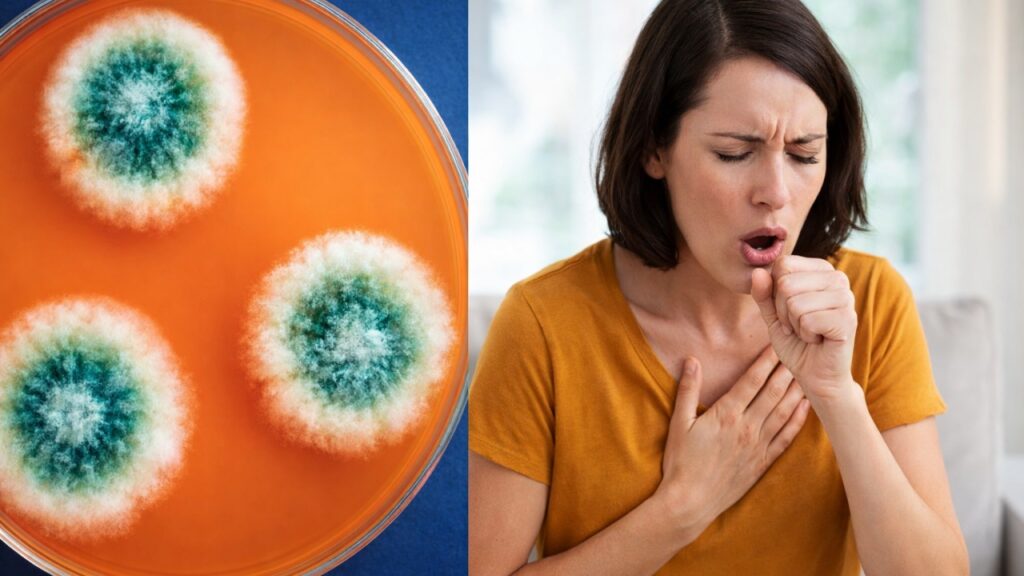
problemi legati alla muffa

La muffa è ovunque: 11 segnali che lo indicano
La muffa è un problema comune nelle abitazioni, con diverse tipologie che possono causare allergie e gravi problemi di salute. Scopri le 11 segnali della malattia ad essa associata
Il problema della muffa è presente in molte abitazioni, ma spesso non è riconosciuto come tale. Sebbene la maggior parte delle persone controlli aree specifiche come la doccia, il lavandino o il seminterrato, essa può svilupparsi in diverse altre zone della casa.
Può proliferare su pareti, soffitti, e persino sugli alberi di Natale. Uno studio ha rivelato che anche i tradizionali alberi natalizi possono essere un ricettacolo di muffa, rilasciando milioni di spore nell’ambiente domestico, il che può provocare allergie invernali e attacchi d’asma. Durante i quattordici giorni in cui un albero di Natale rimane in casa, la qualità dell’aria interna può diminuire fino a sei volte rispetto alla norma.
Tipologie di muffa e il loro impatto
Ci sono migliaia di varietà di muffa che possono essere riscontrate con crescente frequenza nelle abitazioni moderne. Gli scienziati classificano questi tipi in base agli effetti che hanno sulla salute umana e su altri organismi viventi.
Allergeniche
Le muffe allergeniche sono considerate di bassa pericolosità e causano problemi principalmente a chi soffre di asma o allergie specifiche. I bambini sono particolarmente vulnerabili a queste allergie rispetto agli adulti. La presenza di questo tipo può scatenare reazioni che vanno da lievi a moderate, influenzando la qualità della vita di chi ne soffre.
Patogene
Le patogene hanno la capacità di provocare infezioni, rappresentando un rischio significativo per le persone con un sistema immunitario compromesso. L’esposizione a questo tipo di muffe può causare sintomi simili a quelli di una polmonite batterica, rendendo necessaria una particolare attenzione in contesti sanitari e in abitazioni con individui vulnerabili.
Tossiche
Le muffe tossiche producono micotossine che possono avere effetti gravi sulla salute. Queste sostanze chimiche tossiche possono essere assorbite dal corpo attraverso l’inalazione, l’ingestione o il contatto diretto. Sono state associate a problematiche come l’immunosoppressione e il cancro, rendendo importante la loro identificazione e rimozione dagli ambienti domestici.
Tipi comuni di muffa negli ambienti interni

Secondo esperti, le cinque muffe più frequentemente riscontrate negli ambienti interni sono:
Alternaria: Questo tipo è comunemente trovato nel tratto respiratorio e può causare reazioni allergiche.
Aspergillus: Tipico di climi caldi e umidi, è spesso presente nella polvere domestica e può provocare infezioni polmonari.
Cladosporium: Sebbene sia comune all’esterno, può anche crescere all’interno su materiali porosi e umidi, causando sintomi allergici.
Penicillium: Questa muffa si trova frequentemente in materiali come carta da parati e tappeti, e può causare allergie e asma, con alcune specie che producono micotossine.
Stachybotrys: Conosciuta come “muffa nera”, è altamente tossica e può causare gravi problemi respiratori. Anche se meno comune, può essere trovata su materiali come legno e carta.
Comprendere la malattia da muffa
La malattia da muffa si riferisce a una serie di problemi di salute che possono derivare dall’esposizione ad essa. Mentre l’allergia alla muffa è una delle problematiche più comuni, le conseguenze possono variare, includendo infezioni e reazioni tossiche. Le infezioni fungine possono manifestarsi con una gamma di sintomi, che vanno da quelli simili a un raffreddore a condizioni più gravi come la polmonite.
Segnali di allerta della malattia
Esistono undici segnali che possono indicare la malattia da muffa, tra cui:
Problemi di memoria e concentrazione, insieme a mal di testa.
Affaticamento e debolezza generali.
Crampi muscolari e dolori articolari inexplicabili.
Formicolio e intorpidimento.
Problemi oculari come arrossamento e sensibilità alla luce.
Asma e difficoltà respiratorie.
Tremori e vertigini.
Disturbi gastrointestinali, inclusi cambiamenti nell’appetito e nausea.
Sapore metallico in bocca.
Alterazioni nella regolazione della temperatura e sudorazione notturna.
Aumento della sete e della frequenza urinaria.
La diffusione di queste informazioni è cruciale per migliorare la consapevolezza riguardo ai rischi sanitari associati alla muffa, contribuendo così a una maggiore protezione per la salute pubblica